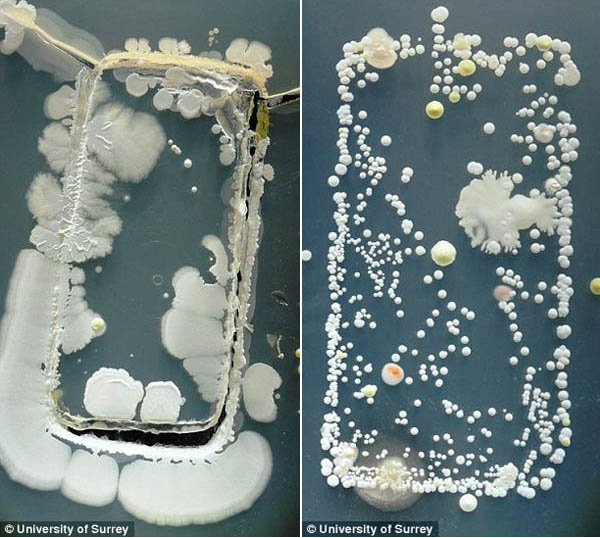

(출처=서리대학교)
항상 손에서 떼놓지 않는 스마트폰 단말기가 세균의 온상임을 보여주는 실험이 나왔다. 15일(현지시간) 영국 데일리메일은 스마트폰 단말기의 세균배양 실험을 보도했다. 영국 서리대학교(University of Surrey) 학생들이 실시한 이 실험은 배양접시에 스마트폰 단말기를 넣은 뒤 3일간 세균증식을 관찰한 것. 관찰 결과 스마트폰 표면에 있던 박테리아가 엄청나게 증식했으며, 세균수는 화장실 변기보다 18배 더 많은 것으로 나타났다. 스마트폰에서 발견된 박테리아는 황색 포도상 구균, 바실러스 마이코이데스 등으로 대부분은 건강에 악영향을 주는 종류는 아닌 것으로 전해졌다.




